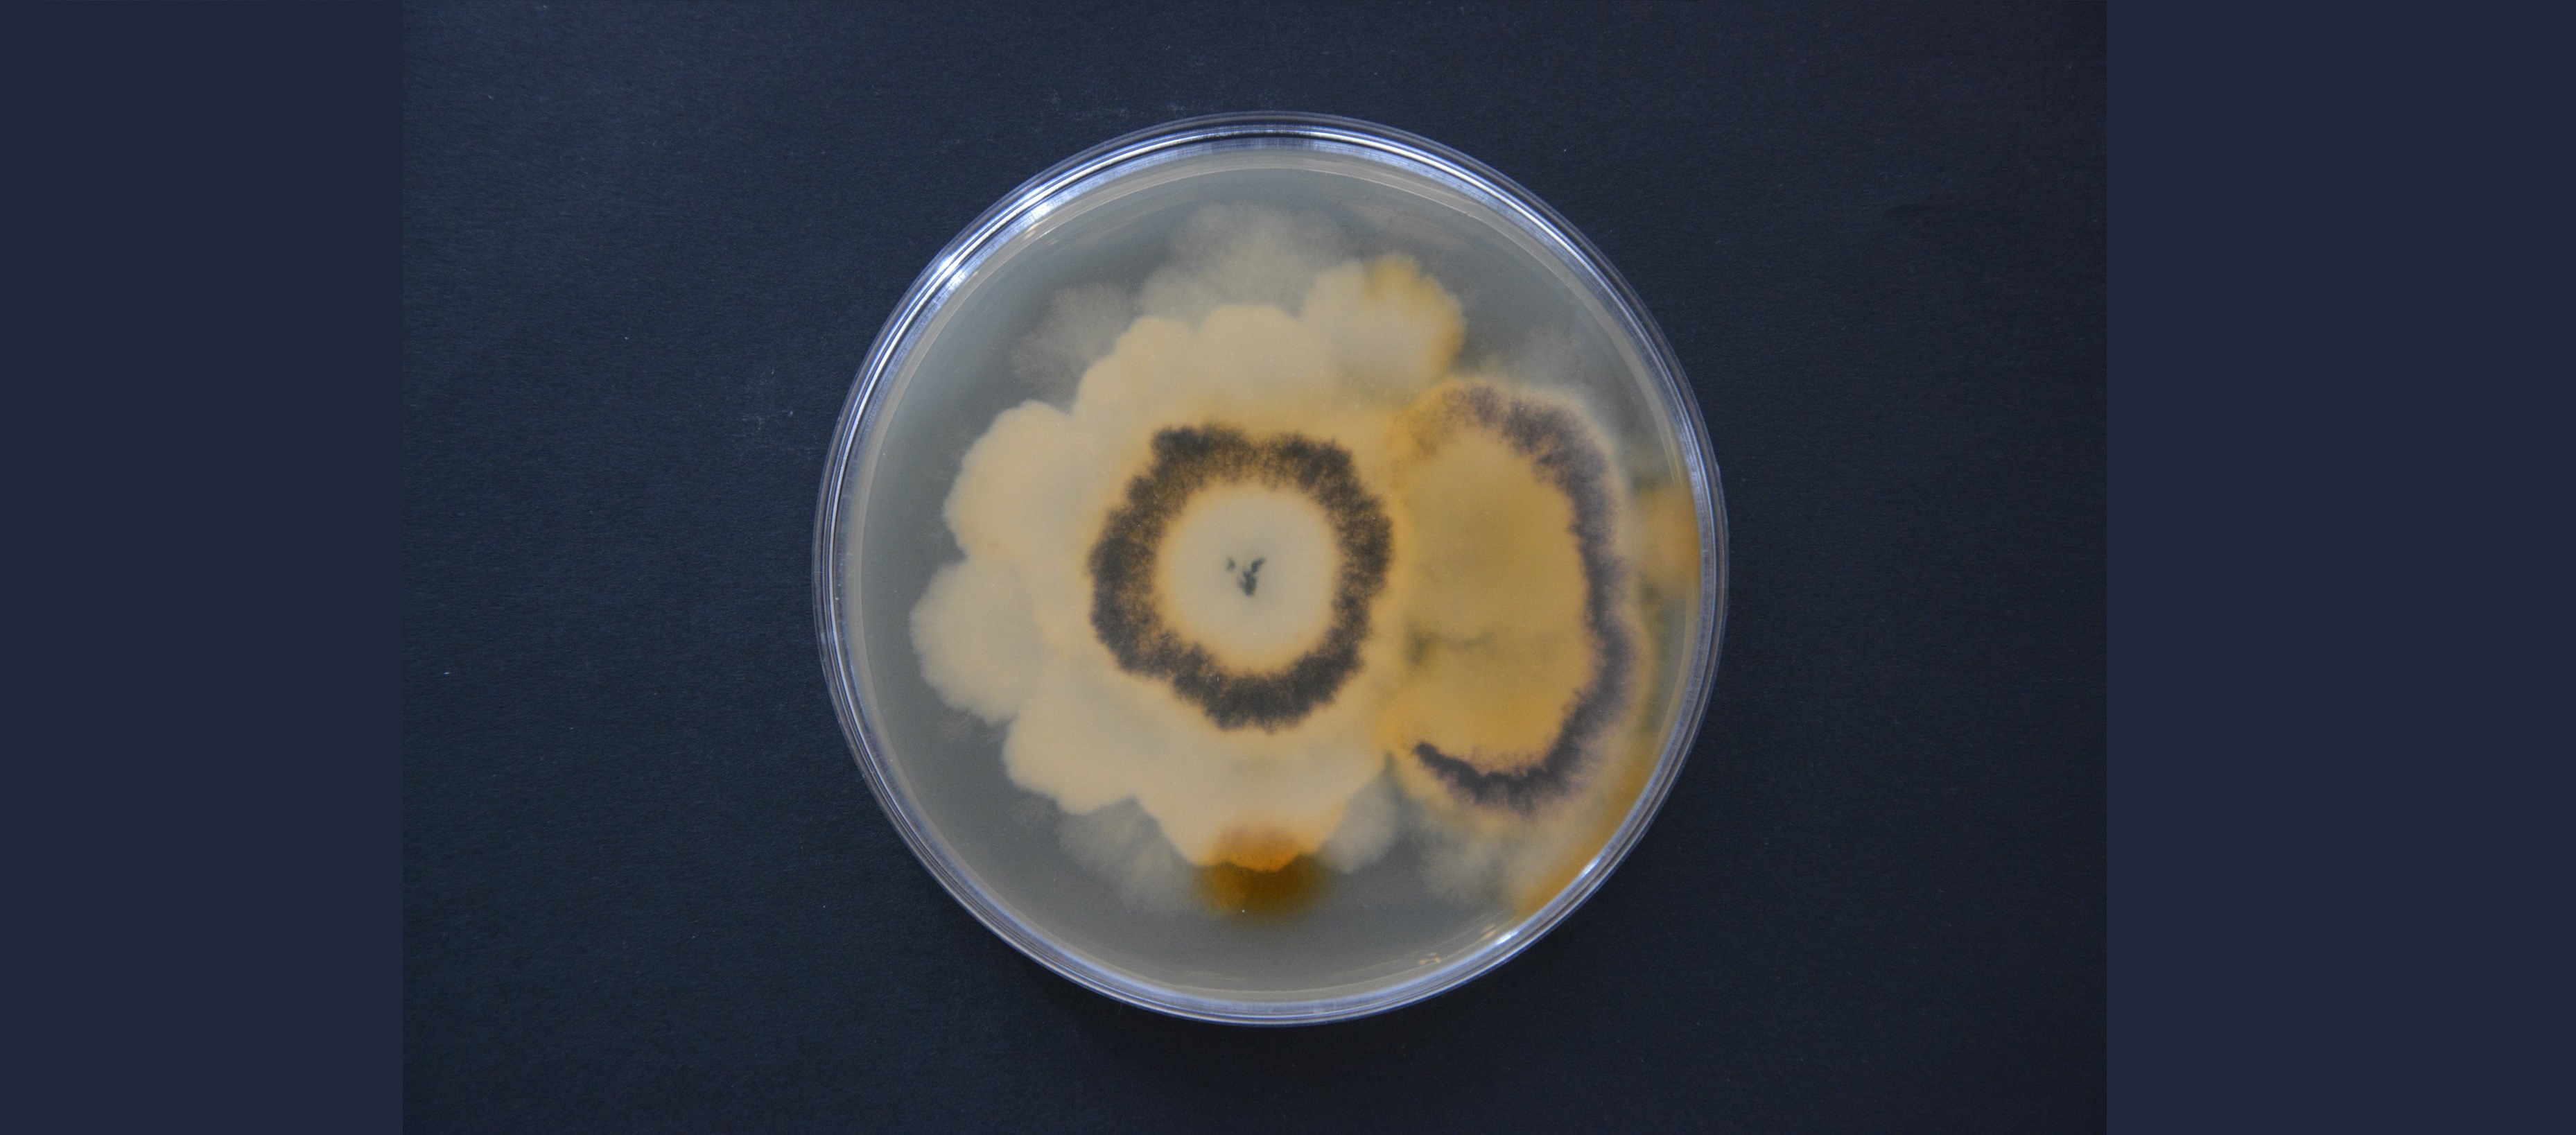
Grzyby w walce ze szkodliwymi substancjami

W ciągu ostatnich kilkudziesięciu lat, wraz z rozwojem przemysłu, wprowadzono wiele nowych technologii, mających na celu zmniejszenie kosztów produkcji oraz zwiększenie jakości wytwarzanych produktów. Stąd też, zaczęto wykorzystywać związki endokrynnie czynne. Wykorzystywane są głównie do wyrobu plastiku, ze względu na niską cenę oraz trwałość otrzymywanego materiału, ale także do wytwarzania kosmetyków, detergentów oraz pestycydów, z uwagi na łatwość łączenia się z innymi składnikami.
Związki te są wrażliwe na zmianę warunków środowiska, dlatego łatwo migrują z plastikowych opakowań i butelek do żywności. Oprócz tego ich śladowe ilości występują w warzywach oraz owocach, jako pozostałości po stosowanych pestycydach. Doprowadza to do mimowolnego przenikania tych związków do organizmu człowieka oraz środowiska. Niestety, pomimo pożytecznego wykorzystania w przemyśle nie pozostają obojętne dla organizmu.
Związki endokrynnie czynne budową przypominają cząsteczki hormonów płciowych, dlatego w łatwy sposób mogą naśladować ich działanie, doprowadzając do zaburzeń w funkcjonowaniu układu hormonalnego, już nawet w niewielkich stężeniach. To prowadzi do zakłócenia pracy jajników oraz jąder i może być przyczyną niepłodności. Oprócz tego stwierdzono, że związki te mogą przyczynić się do powstawania chorób metabolicznych jak otyłość czy cukrzyca typu II.
W związku z zagrożeniem dla zdrowia, jakie niosą związki endokrynnie czynnie, w ciągu ostatnich lat zaczęto wprowadzać kolejne restrykcje dotyczące stosowania tych związków w produktach, mających kontakt z żywnością. Pomimo tego, duża ich ilość w dalszym ciągu dostaje się do środowiska. Tradycyjne oczyszczalnie ścieków stosują zarówno metody fizyczne jaki i chemiczne w celu pozbycia się tego zanieczyszczenia. Jednak okazują się one mało efektywne, gdyż w oczyszczonych ściekach w dalszym ciągu znajdowane są te związki w niepokojących stężeniach, co stanowi bezpośrednie zagrożenie dla zwierząt wodnych, a pośrednie także dla nas.
Zaczęto więc poszukiwać bardziej ekonomicznych oraz ekologicznych metod, które usunęłyby te związki z otoczenia. Rozwiązaniem okazały się grzyby, zasiedlające drzewa strefy umiarkowanej, zwane grzybami białej zgnilizny drewna. Naturalnie grzyby te uczestniczą w rozkładzie kory drewna, powodując na niej biały nalot, skąd pochodzi ich nazwa. Możliwe jest to, dzięki wydzielaniu przez nie enzymów rozkładających poszczególne elementy drewna. Okazuje się, że enzymy te zdolne są również do rozkładu wielu substancji chemicznych, w tym związków endokrynnie czynnych.
W warunkach laboratoryjnych udało się uzyskać nawet do 100% degradacji tych związków, przy użyciu wspomnianych enzymów. Przeszkodą w stosowaniu grzybów w warunkach naturalnych, na szeroką skalę jest obecność bakterii w zbiornikach wodnych, które mogą obniżać skuteczność degradacji, dlatego trwają prace nad optymalizacją procesu.
Zastosowanie grzybów białej zgnilizny drewna w środowisku byłoby doskonałym rozwiązaniem technologicznym i pomogłoby wyeliminować obecność szkodliwych związków w otoczeniu oraz wykluczyć zagrożenie ludzi oraz zwierząt.
Opracowano na podstawie artykułów:
Coster, S. De, & Larebeke, N. Van. (2012). Endocrine-Disrupting Chemicals : Associated Disorders and Mechanisms of Action, 2012. https://doi.org/10.1155/2012/713696
Schug, T. T., Janesick, A., Blumberg, B., & Heindel, J. J. (2011). Journal of Steroid Biochemistry and Molecular Biology Endocrine disrupting chemicals and disease susceptibility. Journal of Steroid Biochemistry and Molecular Biology, 127(3–5), 204–215. https://doi.org/10.1016/j.jsbmb.2011.08.007
Rogers, J. A., Metz, L., & Yong, V. W. (2013). Review : Endocrine disrupting chemicals and immune responses : A focus on bisphenol-A and its potential mechanisms. Molecular Immunology, 53 (4), 421–430. https://doi.org/10.1016/j.molimm.2012.09.013
Yang, S., Hai, F. I., Nghiem, L. D., Price, W. E., Roddick, F., Moreira, M. T., & Magram, S. F. (2013). Bioresource Technology Understanding the factors controlling the removal of trace organic contaminants by white-rot fungi and their lignin modifying enzymes : A critical review. Bioresource Technology, 141, 97–108. https://doi.org/10.1016/j.biortech.2013.01.173
Artykuł powstał w ramach programu "Tutoring dla najlepszych studentów Uniwersytetu Śląskiego", we współpracy między p. Agnieszką Grelską, studentką biotechnologii i dr Magdaleną Noszczyńską z Wydziału Biologii i Ochrony Środowiska Uniwersytetu Śląskiego w Katowicach. Informacja na temat programu: http://www.tutor.us.edu.pl/